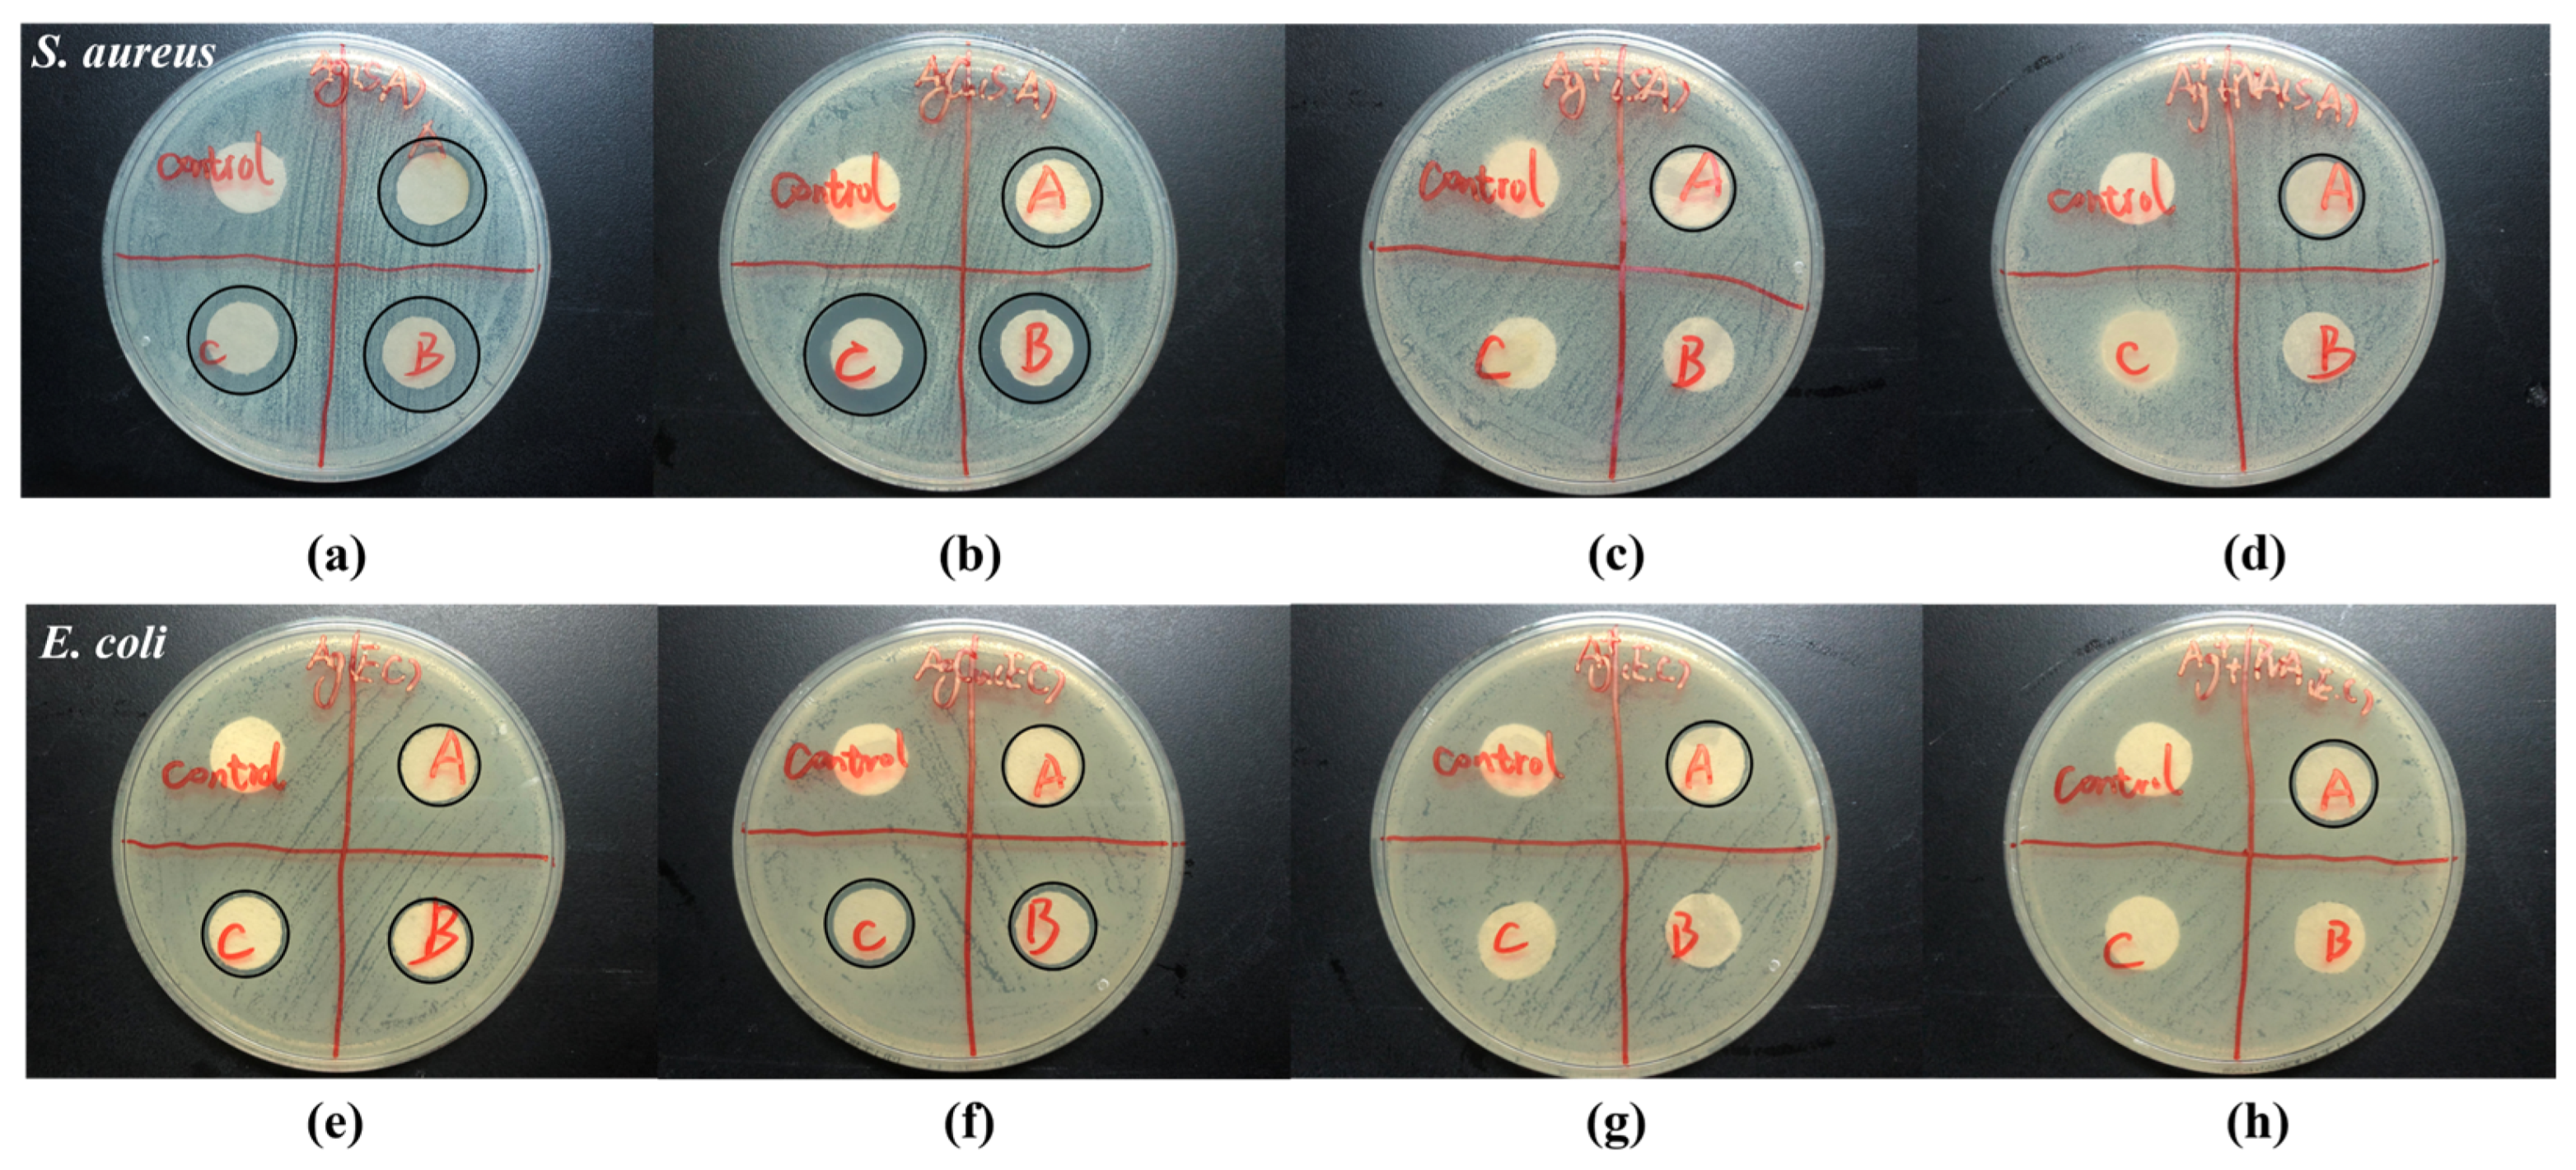

The Enhanced Durability of AgCu Nanoparticle Coatings for Antibacterial Nonwoven Air Conditioner Filters
Abstract
1. Introduction
2. Results
3. Discussion
4. Materials and Methods
4.1. Materials
4.2. Sample Preparation
4.3. Characterization
4.4. Antibacterial Evaluations
4.5. Statistical Studies
5. Conclusions
Supplementary Materials
Author Contributions
Funding
Institutional Review Board Statement
Informed Consent Statement
Data Availability Statement
Acknowledgments
Conflicts of Interest
References
- Lee, H.J.; Yeo, S.Y.; Jeong, S.H. Antibacterial effect of nanosized silver colloidal solution on textile fabrics. J. Mater. Sci. 2003, 38, 2199–2204. [Google Scholar] [CrossRef]
- Nowack, B.; Krug, H.F.; Height, M. 120 Years of Nanosilver History: Implications for Policy Makers. Environ. Sci. Technol. 2011, 45, 1177–1183. [Google Scholar] [CrossRef] [PubMed]
- Shah, M.A.; Pirzada, B.M.; Price, G.; Shibiru, A.L.; Qurashi, A. Applications of nanotechnology in smart textile industry: A critical review. J. Adv. Res. 2022, 38, 55–75. [Google Scholar] [PubMed]
- Bhandari, V.; Jose, S.; Badanayak, P.; Sankaran, A.; Anandan, V. Antimicrobial finishing of metals, metal oxides, and metal composites on textiles: A systematic review. Ind. Eng. Chem. Res. 2022, 61, 86–101. [Google Scholar] [CrossRef]
- Begam, R.; Joshi, M.; Purwar, R. Antimicrobial Finishing of Cotton Textiles Using Silver Intercalated Clay. Fibers Polym. 2022, 23, 148–154. [Google Scholar] [CrossRef]
- Blevens, M.S.; Pastrana, H.F.; Mazzotta, H.C.; Tsai, C.S.-J. Cloth face masks containing silver: Evaluating the status. ACS Chem. Health Saf. 2021, 28, 171–182. [Google Scholar] [CrossRef]
- Hamouda, T.; Kafafy, H.; Mashaly, H.; Aly, N.M. Breathability performance of antiviral cloth masks treated with silver nanoparticles for protection against COVID-19. J. Ind. Text. 2022, 51, 1494–1523. [Google Scholar] [CrossRef]
- Praveena, S.M.; Aris, A.Z. Application of low-cost materials coated with silver nanoparticle as water filter in Escherichia coli removal. Water Qual. Expo. Health 2015, 7, 617–625. [Google Scholar] [CrossRef]
- Joe, Y.H.; Ju, W.; Park, J.H.; Yoon, Y.H.; Hwang, J. Correlation between the antibacterial ability of silver nanoparticle coated air filters and the dust loading. Aerosol Air Qual. Res. 2013, 13, 1009–1018. [Google Scholar] [CrossRef]
- Ju, Y.; Han, T.; Yin, J.; Li, Q.; Chen, Z.; Wei, Z.; Zhang, Y.; Dong, L. Bumpy structured nanofibrous membrane as a highly efficient air filter with antibacterial and antiviral property. Sci. Total Environ. 2021, 777, 145768. [Google Scholar] [CrossRef]
- Balagna, C.; Perero, S.; Bosco, F.; Mollea, C.; Irfan, M.; Ferraris, M. Antipathogen nanostructured coating for air filters. Appl. Surf. Sci. 2020, 508, 145283. [Google Scholar] [CrossRef]
- Ko, Y.-S.; Joe, Y.H.; Seo, M.; Lim, K.; Hwang, J.; Woo, K. Prompt and synergistic antibacterial activity of silver nanoparticle-decorated silica hybrid particles on air filtration. J. Mater. Chem. B 2014, 2, 6714–6722. [Google Scholar] [CrossRef] [PubMed]
- Joe, Y.H.; Yoon, K.Y.; Hwang, J. Methodology for modeling the microbial contamination of air filters. PLoS ONE 2014, 9, e88514. [Google Scholar] [CrossRef]
- Maneerung, T.; Tokura, S.; Rujiravanit, R. Impregnation of silver nanoparticles into bacterial cellulose for antimicrobial wound dressing. Carbohydr. Polym. 2008, 72, 43–51. [Google Scholar] [CrossRef]
- Krishnan, P.D.; Banas, D.; Durai, R.D.; Kabanov, D.; Hosnedlova, B.; Kepinska, M.; Fernandez, C.; Ruttkay-Nedecky, B.; Nguyen, H.V.; Farid, A. Silver nanomaterials for wound dressing applications. Pharmaceutics 2020, 12, 821. [Google Scholar] [CrossRef]
- Joe, Y.H.; Park, D.H.; Hwang, J. Evaluation of Ag nanoparticle coated air filter against aerosolized virus: Anti-viral efficiency with dust loading. J. Hazard. Mater. 2016, 301, 547–553. [Google Scholar] [CrossRef]
- Joe, Y.H.; Woo, K.; Hwang, J. Fabrication of an anti-viral air filter with SiO2–Ag nanoparticles and performance evaluation in a continuous airflow condition. J. Hazard. Mater. 2014, 280, 356–363. [Google Scholar] [CrossRef]
- Hiragond, C.B.; Kshirsagar, A.S.; Dhapte, V.V.; Khanna, T.; Joshi, P.; More, P.V. Enhanced anti-microbial response of commercial face mask using colloidal silver nanoparticles. Vacuum 2018, 156, 475–482. [Google Scholar] [CrossRef]
- Balagna, C.; Perero, S.; Percivalle, E.; Nepita, E.V.; Ferraris, M. Virucidal effect against coronavirus SARS-CoV-2 of a silver nanocluster/silica composite sputtered coating. Open Ceram. 2020, 1, 100006. [Google Scholar] [CrossRef]
- Liao, M.; Liu, H.; Wang, X.; Hu, X.; Huang, Y.; Liu, X.; Brenan, K.; Mecha, J.; Nirmalan, M.; Lu, J.R. A technical review of face mask wearing in preventing respiratory COVID-19 transmission. Curr. Opin. Colloid Interface Sci. 2021, 52, 101417. [Google Scholar] [CrossRef]
- Pollard, Z.A.; Karod, M.; Goldfarb, J.L. Metal leaching from antimicrobial cloth face masks intended to slow the spread of COVID-19. Sci. Rep. 2021, 11, 19216. [Google Scholar] [CrossRef] [PubMed]
- Behbudi, G. Effect of silver nanoparticles disinfectant on COVID-19. Adv. Appl. NanoBio-Technol. 2021, 2, 63–67. [Google Scholar]
- Mallakpour, S.; Azadi, E.; Hussain, C.M. Fabrication of air filters with advanced filtration performance for removal of viral aerosols and control the spread of COVID-19. Adv. Colloid Interface Sci. 2022, 303, 102653. [Google Scholar] [CrossRef] [PubMed]
- Watson, R.; Oldfield, M.; Bryant, J.A.; Riordan, L.; Hill, H.J.; Watts, J.A.; Alexander, M.R.; Cox, M.J.; Stamataki, Z.; Scurr, D.J. Efficacy of antimicrobial and anti-viral coated air filters to prevent the spread of airborne pathogens. Sci. Rep. 2022, 12, 2803. [Google Scholar] [CrossRef] [PubMed]
- Arora, N.; Thangavelu, K.; Karanikolos, G.N. Bimetallic nanoparticles for antimicrobial applications. Front. Chem. 2020, 8, 412. [Google Scholar] [CrossRef]
- Sharma, G.; Kumar, A.; Sharma, S.; Naushad, M.; Dwivedi, R.P.; ALOthman, Z.A.; Mola, G.T. Novel development of nanoparticles to bimetallic nanoparticles and their composites: A review. J. King Saud Univ. Sci. 2019, 31, 257–269. [Google Scholar] [CrossRef]
- Zare, E.N.; Padil, V.V.; Mokhtari, B.; Venkateshaiah, A.; Wacławek, S.; Černík, M.; Tay, F.R.; Varma, R.S.; Makvandi, P. Advances in biogenically synthesized shaped metal-and carbon-based nanoarchitectures and their medicinal applications. Adv. Colloid Interface Sci. 2020, 283, 102236. [Google Scholar] [CrossRef]
- Makvandi, P.; Wang, C.Y.; Zare, E.N.; Borzacchiello, A.; Niu, L.n.; Tay, F.R. Metal-based nanomaterials in biomedical applications: Antimicrobial activity and cytotoxicity aspects. Adv. Funct. Mater. 2020, 30, 1910021. [Google Scholar] [CrossRef]
- Zhou, F.; Zhu, Y.; Yang, L.; Yang, D.-Q.; Sacher, E. Ag NP catalysis of Cu ions in the preparation of AgCu NPs and the mechanism of their enhanced antibacterial efficacy. Colloids Surf. A Physicochem. Eng. Asp. 2022, 632, 127831. [Google Scholar] [CrossRef]
- Tao, Y.; Zhou, F.; Wang, K.; Yang, D.; Sacher, E. AgCu NP Formation by the Ag NP Catalysis of Cu Ions at Room Temperature and Their Antibacterial Efficacy: A Kinetic Study. Molecules 2022, 27, 6951. [Google Scholar] [CrossRef]
- Zhu, Y.; Zhou, F.; Hu, J.; Yang, L.; Yang, D.-Q.; Sacher, E. A facile route to prepare colorless Ag-Cu nanoparticle dispersions with elevated antibacterial effects. Colloids Surf. A Physicochem. Eng. Asp. 2021, 626, 127116. [Google Scholar] [CrossRef]
- Taner, M.; Sayar, N.; Yulug, I.G.; Suzer, S. Synthesis, characterization and antibacterial investigation of silver–copper nanoalloys. J. Mater. Chem. 2011, 21, 13150–13154. [Google Scholar] [CrossRef]
- Tan, K.S.; Cheong, K.Y. Advances of Ag, Cu, and Ag–Cu alloy nanoparticles synthesized via chemical reduction route. J. Nanoparticle Res. 2013, 15, 1537. [Google Scholar] [CrossRef]
- Paszkiewicz, M.; Gołąbiewska, A.; Rajski, Ł.; Kowal, E.; Sajdak, A.; Zaleska-Medynska, A. Synthesis and characterization of monometallic (Ag, Cu) and bimetallic Ag-Cu particles for antibacterial and antifungal applications. J. Nanomater. 2016, 2016, 2187940. [Google Scholar] [CrossRef]
- Valdez-Salas, B.; Beltrán-Partida, E.; Zlatev, R.; Stoytcheva, M.; Gonzalez-Mendoza, D.; Salvador-Carlos, J.; Moreno-Ulloa, A.; Cheng, N. Structure-activity relationship of diameter controlled Ag@ Cu nanoparticles in broad-spectrum antibacterial mechanism. Mater. Sci. Eng. C 2021, 119, 111501. [Google Scholar] [CrossRef] [PubMed]
- Wang, X.; Li, R.; Li, Z.; Xiao, R.; Chen, X.-B.; Zhang, T. Design and preparation of nanoporous Ag–Cu alloys by dealloying Mg–(Ag, Cu)–Y metallic glasses for antibacterial applications. J. Mater. Chem. B 2019, 7, 4169–4176. [Google Scholar] [CrossRef]
- Yang, L.; Chen, L.; Chen, Y.-C.; Kang, L.; Yu, J.; Wang, Y.; Lu, C.; Mashimo, T.; Yoshiasa, A.; Lin, C.-H. Homogeneously alloyed nanoparticles of immiscible Ag–Cu with ultrahigh antibacterial activity. Colloids Surf. B Biointerfaces 2019, 180, 466–472. [Google Scholar] [CrossRef]
- Liu, X.; Du, J.; Shao, Y.; Zhao, S.-F.; Yao, K.-F. One-pot preparation of nanoporous Ag-Cu@ Ag core-shell alloy with enhanced oxidative stability and robust antibacterial activity. Sci. Rep. 2017, 7, 10249. [Google Scholar] [CrossRef]
- Fan, X.; Yahia, L.H.; Sacher, E. Antimicrobial properties of the Ag, Cu nanoparticle system. Biology 2021, 10, 137. [Google Scholar] [CrossRef]
- Zhou, F.; Kostantin, E.; Yang, D.-Q.; Sacher, E. Cytotoxicity and Antibacterial Efficacy of AgCu and AgFe NanoAlloys: A Comparative Study. Antibiotics 2022, 11, 1737. [Google Scholar] [CrossRef]
- Xu, Q.; Xie, L.; Diao, H.; Li, F.; Zhang, Y.; Fu, F.; Liu, X. Antibacterial cotton fabric with enhanced durability prepared using silver nanoparticles and carboxymethyl chitosan. Carbohydr. Polym. 2017, 177, 187–193. [Google Scholar] [CrossRef] [PubMed]
- Zhang, D.; Chen, L.; Zang, C.; Chen, Y.; Lin, H. Antibacterial cotton fabric grafted with silver nanoparticles and its excellent laundering durability. Carbohydr. Polym. 2013, 92, 2088–2094. [Google Scholar] [CrossRef] [PubMed]
- Wu, M.; Ma, B.; Pan, T.; Chen, S.; Sun, J. Silver-nanoparticle-colored cotton fabrics with tunable colors and durable antibacterial and self-healing superhydrophobic properties. Adv. Funct. Mater. 2016, 26, 569–576. [Google Scholar] [CrossRef]
- Sreekumar, T.; Das, A.; Chandra, L.; Srivastava, A.; Rao, B.K. Inherently colored antimicrobial fibers employing silver nanoparticles. J. Biomed. Nanotechnol. 2009, 5, 115–120. [Google Scholar] [CrossRef]
- Bluyssen, P.M.; Ortiz, M.; Zhang, D. The effect of a mobile HEPA filter system on ‘infectious’ aerosols, sound and air velocity in the SenseLab. Build. Environ. 2021, 188, 107475. [Google Scholar] [CrossRef] [PubMed]
- Szczotko, M.; Orych, I.; Mąka, Ł.; Solecka, J. A review of selected types of indoor air purifiers in terms of microbial air contamination reduction. Atmosphere 2022, 13, 800. [Google Scholar] [CrossRef]
- Christopherson, D.A.; Yao, W.C.; Lu, M.; Vijayakumar, R.; Sedaghat, A.R. High-efficiency particulate air filters in the era of COVID-19: Function and efficacy. Otolaryngol. Head Neck Surg. 2020, 163, 1153–1155. [Google Scholar] [CrossRef]
- Fadil, F.; Affandi, N.D.N.; Misnon, M.I.; Bonnia, N.N.; Harun, A.M.; Alam, M.K. Review on electrospun nanofiber-applied products. Polymers 2021, 13, 2087. [Google Scholar] [CrossRef]
- Borojeni, I.A.; Gajewski, G.; Riahi, R.A. Application of Electrospun Nonwoven Fibers in Air Filters. Fibers 2022, 10, 15. [Google Scholar] [CrossRef]
- Montazer, M.; Alimohammadi, F.; Shamei, A.; Rahimi, M.K. Durable antibacterial and cross-linking cotton with colloidal silver nanoparticles and butane tetracarboxylic acid without yellowing. Colloids Surf. B Biointerfaces 2012, 89, 196–202. [Google Scholar] [CrossRef]
- Zhang, Y.; Li, Y.; Hu, Q. Colorless antibacterial cotton fabrics based on silver nanoparticles and chitosan complexes. Int. J. Cloth. Sci. Technol. 2012, 24, 118–128. [Google Scholar] [CrossRef]
- Richardson, J.J.; Liao, W.; Li, J.; Cheng, B.; Wang, C.; Maruyama, T.; Tardy, B.L.; Guo, J.; Zhao, L.; Aw, W. Rapid assembly of colorless antimicrobial and anti-odor coatings from polyphenols and silver. Sci. Rep. 2022, 12, 2071. [Google Scholar] [CrossRef] [PubMed]
- La, D.D.; Pham, K.T.T.; Lai, H.T.; Tran, D.L.; Van Bui, C.; Nguyen, P.H.T.; Chang, S.W.; Um, M.-J.; Nguyen, D.D. Fabrication of Antibacterial Ag/Graphene-Integrated Non-Woven Polypropylene Textile for Air Pollutant Filtering. Waste Biomass Valorization 2023. [Google Scholar] [CrossRef] [PubMed]
- Shiu, B.-C.; Zhang, Y.; Yuan, Q.; Lin, J.-H.; Lou, C.-W.; Li, Y. Preparation of Ag@ ZIF-8@ PP melt-blown nonwoven fabrics: Air filter efficacy and antibacterial effect. Polymers 2021, 13, 3773. [Google Scholar] [CrossRef] [PubMed]
- Raha, S.; Mallick, R.; Basak, S.; Duttaroy, A.K. Is copper beneficial for COVID-19 patients? Med. Hypotheses 2020, 142, 109814. [Google Scholar] [CrossRef] [PubMed]
- Govind, V.; Bharadwaj, S.; Sai Ganesh, M.; Vishnu, J.; Shankar, K.V.; Shankar, B.; Rajesh, R. Antiviral properties of copper and its alloys to inactivate COVID-19 virus: A review. Biometals 2021, 34, 1217–1235. [Google Scholar] [CrossRef] [PubMed]
- Jagaran, K.; Singh, M. Nanomedicine for COVID-19: Potential of copper nanoparticles. Biointerface Res. Appl. Chem. 2020, 11, 10716–10728. [Google Scholar]
- Perelshtein, I.; Levi, I.; Perkas, N.; Pollak, A.; Gedanken, A. CuO-Coated Antibacterial and Antiviral Car Air-Conditioning Filters. ACS Appl. Mater. Interfaces 2022, 14, 24850–24855. [Google Scholar] [CrossRef]
- Druvari, D.; Tzoumani, I.; Piperigkou, Z.; Tzaferi, K.; Tselentis, D.; Vlamis-Gardikas, A.; Karamanos, N.K.; Bokias, G.; Kallitsis, J.K. Development of Environmentally Friendly Biocidal Coatings Based on Water-Soluble Copolymers for Air-Cleaning Filters. ACS Omega 2022, 7, 35204–35216. [Google Scholar] [CrossRef]
- Park, K.; Kang, S.; Park, J.-W.; Hwang, J. Fabrication of silver nanowire coated fibrous air filter medium via a two-step process of electrospinning and electrospray for anti-bioaerosol treatment. J. Hazard. Mater. 2021, 411, 125043. [Google Scholar] [CrossRef]
- Simončič, B.; Klemenčič, D. Preparation and performance of silver as an antimicrobial agent for textiles: A review. Text. Res. J. 2016, 86, 210–223. [Google Scholar] [CrossRef]
- Attia, N.F.; Elashery, S.E.; Oh, H. Nanomaterials-based antibacterial textiles. In Nanosensors and Nanodevices for Smart Multifunctional Textiles; Elsevier: Amsterdam, The Netherlands, 2021; pp. 135–147. [Google Scholar]
- Das, C.A.; Kumar, V.G.; Dhas, T.S.; Karthick, V.; Govindaraju, K.; Joselin, J.M.; Baalamurugan, J. Antibacterial activity of silver nanoparticles (biosynthesis): A short review on recent advances. Biocatal. Agric. Biotechnol. 2020, 27, 101593. [Google Scholar] [CrossRef]
- Kim, M.; Saito, K.J.R.; Polymers, F. Preparation of silver-ion-loaded nonwoven fabric by radiation-induced graft polymerization. React. Funct. Polym. 1999, 40, 275–279. [Google Scholar] [CrossRef]
- Zhou, J.; Yan, Y.; Zhang, Y.; Zhang, Y.; Zhang, D.; Lin, H.; Chen, Y.; Zhao, B.; Xiong, J. Amino-terminated hyperbranched polymer functionalized graphene oxide with in situ trapped silver nanoparticles for high-performance antibacterial nonwoven fabric. J. Appl. Polym. Sci. 2023, 140, e53466. [Google Scholar] [CrossRef]
- Goli, K.K.; Gera, N.; Liu, X.; Rao, B.M.; Rojas, O.J.; Genzer, J. Generation and properties of antibacterial coatings based on electrostatic attachment of silver nanoparticles to protein-coated polypropylene fibers. ACS Appl. Mater. Interfaces 2013, 5, 5298–5306. [Google Scholar] [CrossRef] [PubMed]
- Ilic, V.; Šaponjić, Z.; Vodnik, V.; Lazović, S.A.; Dimitrijevic, S.; Jovancic, P.; Nedeljkovic, J.M.; Radetic, M. Bactericidal efficiency of silver nanoparticles deposited onto radio frequency plasma pretreated polyester fabrics. Ind. Eng. Chem. Res. 2010, 49, 7287–7293. [Google Scholar] [CrossRef]
- Voznesensky, E.; Timoshina, Y.; Karimullin, I.; Anisimova, N.Y.; Larin, I.; Statnik, E. Plasma methods for preparation of the substrate and fixing the nanoparticles in the obtaining of disposable antibacterial synthetic materials. Mater. Lett. 2022, 308, 131193. [Google Scholar] [CrossRef]
- Shen, T.; Liu, Y.; Zhu, Y.; Yang, D.-Q.; Sacher, E. Improved adhesion of Ag NPs to the polyethylene terephthalate surface via atmospheric plasma treatment and surface functionalization. Appl. Surf. Sci. 2017, 411, 411–418. [Google Scholar] [CrossRef]
- Chawla, S.; Sankarraman, N.; Payer, J. Diagnostic spectra for XPS analysis of Cu O S H compounds. J. Electron Spectrosc. Relat. Phenom. 1992, 61, 1–18. [Google Scholar] [CrossRef]
- Yang, D.-Q.; Meunier, M.; Sacher, E. The estimation of the average dimensions of deposited clusters from XPS emission intensity ratios. Appl. Surf. Sci. 2001, 173, 134–139. [Google Scholar] [CrossRef]
- Baer, D.R. Guide to making XPS measurements on nanoparticles. J. Vac. Sci. Technol. A Vac. Surf. Film. 2020, 38, 031201. [Google Scholar] [CrossRef]
- Hu, J.; Yang, L.; Zhu, Y.; Yang, D.-Q.; Sacher, E. Destabilization of PVA-stabilized Ag NPs: Color changes at low aqueous concentrations, induced by aggregation and coalescence. Mater. Res. Express 2020, 7, 025003. [Google Scholar] [CrossRef]
- Lok, C.-N.; Ho, C.-M.; Chen, R.; He, Q.-Y.; Yu, W.-Y.; Sun, H.; Tam, P.K.-H.; Chiu, J.-F.; Che, C.-M. Silver nanoparticles: Partial oxidation and antibacterial activities. JBIC J. Biol. Inorg. Chem. 2007, 12, 527–534. [Google Scholar] [CrossRef] [PubMed]
- Adamczyk, Z.; Oćwieja, M.; Mrowiec, H.; Walas, S.; Lupa, D. Oxidative dissolution of silver nanoparticles: A new theoretical approach. J. Colloid Interface Sci. 2016, 469, 355–364. [Google Scholar] [CrossRef] [PubMed]
- Abdellatif, A.A.; Alturki, H.N.; Tawfeek, H.M. Different cellulosic polymers for synthesizing silver nanoparticles with antioxidant and antibacterial activities. Sci. Rep. 2021, 11, 84. [Google Scholar] [CrossRef]
- Jin, J.-C.; Xu, Z.-Q.; Dong, P.; Lai, L.; Lan, J.-Y.; Jiang, F.-L.; Liu, Y. One-step synthesis of silver nanoparticles using carbon dots as reducing and stabilizing agents and their antibacterial mechanisms. Carbon 2015, 94, 129–141. [Google Scholar] [CrossRef]
- Emam, H.E.; Manian, A.P.; Široká, B.; Duelli, H.; Redl, B.; Pipal, A.; Bechtold, T. Treatments to impart antimicrobial activity to clothing and household cellulosic-textiles–why “Nano”-silver? J. Clean. Prod. 2013, 39, 17–23. [Google Scholar] [CrossRef]
- Jeong, S.H.; Hwang, Y.H.; Yi, S.C. Antibacterial properties of padded PP/PE nonwovens incorporating nano-sized silver colloids. J. Mater. Sci. 2005, 40, 5413–5418. [Google Scholar] [CrossRef]
- Radić, N.; Obradović, B.M.; Kostić, M.; Dojčinović, B.; Kuraica, M.M.; Černák, M. Deposition of silver ions onto DBD and DCSBD plasma treated nonwoven polypropylene. Surf. Coat. Technol. 2012, 206, 5006–5011. [Google Scholar] [CrossRef]
- Rajeswari, N.; Selvasekarapandian, S.; Sanjeeviraja, C.; Kawamura, J.; Asath Bahadur, S. A study on polymer blend electrolyte based on PVA/PVP with proton salt. Polym. Bull. 2014, 71, 1061–1080. [Google Scholar] [CrossRef]
- Lu, Z.; Rong, K.; Li, J.; Yang, H.; Chen, R. Size-dependent antibacterial activities of silver nanoparticles against oral anaerobic pathogenic bacteria. J. Mater. Sci. Mater. Med. 2013, 24, 1465–1471. [Google Scholar] [CrossRef] [PubMed]
- Shrivastava, S.; Bera, T.; Roy, A.; Singh, G.; Ramachandrarao, P.; Dash, D. Characterization of enhanced antibacterial effects of novel silver nanoparticles. Nanotechnology 2007, 18, 225103. [Google Scholar] [CrossRef] [PubMed]
- Ajitha, B.; Reddy, Y.A.K.; Reddy, P.S. Enhanced antimicrobial activity of silver nanoparticles with controlled particle size by pH variation. Powder Technol. 2015, 269, 110–117. [Google Scholar] [CrossRef]
- Kailasa, S.K.; Park, T.-J.; Rohit, J.V.; Koduru, J.R. Antimicrobial activity of silver nanoparticles. In Nanoparticles in Pharmacotherapy; Elsevier: Amsterdam, The Netherlands, 2019; pp. 461–484. [Google Scholar]
- Alshareef, A.; Laird, K.; Cross, R. Shape-dependent antibacterial activity of silver nanoparticles on Escherichia coli and Enterococcus faecium bacterium. Appl. Surf. Sci. 2017, 424, 310–315. [Google Scholar] [CrossRef]
- Jeong, Y.; Lim, D.W.; Choi, J. Assessment of size-dependent antimicrobial and cytotoxic properties of silver nanoparticles. Adv. Mater. Sci. Eng. 2014, 2014, 763807. [Google Scholar] [CrossRef]
- Tang, S.; Zheng, J. Antibacterial activity of silver nanoparticles: Structural effects. Adv. Healthc. Mater. 2018, 7, 1701503. [Google Scholar] [CrossRef] [PubMed]
- Le Ouay, B.; Stellacci, F. Antibacterial activity of silver nanoparticles: A surface science insight. Nano Today 2015, 10, 339–354. [Google Scholar] [CrossRef]
- Helmlinger, J.; Sengstock, C.; Groß-Heitfeld, C.; Mayer, C.; Schildhauer, T.; Köller, M.; Epple, M. Silver nanoparticles with different size and shape: Equal cytotoxicity, but different antibacterial effects. RSC Adv. 2016, 6, 18490–18501. [Google Scholar] [CrossRef]
- Gonzalez, A.L.; Noguez, C.; Beranek, J.; Barnard, A.S. Size, Shape, Stability, and Color of Plasmonic Silver Nanoparticles. J. Phys. Chem. C 2014, 118, 9128–9136. [Google Scholar] [CrossRef]
- Xiu, Z.-M.; Zhang, Q.-B.; Puppala, H.L.; Colvin, V.L.; Alvarez, P.J. Negligible particle-specific antibacterial activity of silver nanoparticles. Nano Lett. 2012, 12, 4271–4275. [Google Scholar] [CrossRef]
- Jung, W.K.; Koo, H.C.; Kim, K.W.; Shin, S.; Kim, S.H.; Park, Y.H. Antibacterial activity and mechanism of action of the silver ion in Staphylococcus aureus and Escherichia coli. Appl. Environ. Microbiol. 2008, 74, 2171–2178. [Google Scholar] [CrossRef] [PubMed]
- Agnihotri, S.; Mukherji, S.; Mukherji, S. Immobilized silver nanoparticles enhance contact killing and show highest efficacy: Elucidation of the mechanism of bactericidal action of silver. Nanoscale 2013, 5, 7328–7340. [Google Scholar] [CrossRef] [PubMed]
- Wu, Z.; Zhou, W.; Deng, W.; Xu, C.; Cai, Y.; Wang, X. Antibacterial and hemostatic thiol-modified chitosan-immobilized AgNPs composite sponges. ACS Appl. Mater. Interfaces 2020, 12, 20307–20320. [Google Scholar] [CrossRef]
- Lorian, V. Antibiotics in Laboratory Medicine; Antibiotics in Laboratory Medicine, Williams & Wilkins: Baltimore, MD, USA, 1980. [Google Scholar]
- Mb, N.; Sadiki, M.; Ibnsouda, S.K. Methods for in vitro evaluating antimicrobial activity: A review. J. Pharm. Anal. 2016, 6, 71–79. [Google Scholar]
- Gulati, R.; Sharma, S.; Sharma, R.K. Antimicrobial textile: Recent developments and functional perspective. Polym. Bull. 2022, 79, 5747–5771. [Google Scholar] [CrossRef] [PubMed]

| Samples | Blank | Ag NPs | AgCu NPs | Ag Ions | Ag Ions-PVA-PVP |
|---|---|---|---|---|---|
| As prepared | white | beige | yellow | white | light beige |
| 15 days | white | light brown | white | light gray | light gray |
| 30 days | white | light brown | white | light gray | light gray |
| at. % | C1s | O1s | N1s | Ag3d | Cu2p | |
|---|---|---|---|---|---|---|
| Sample | ||||||
| Background (fabric) | 74.55 | 25.45 | -- | -- | -- | |
| Ag (0) | 75.18 | 21.77 | 2.87 | 0.18 | -- | |
| Ag (30 days) | 71.8 | 24.19 | 3.74 | 0.28 | -- | |
| AgCu (0) | 74.88 | 21.14 | 3.38 | 0.17 | 0.43 | |
| AgCu (30 days) | 73.1 | 22.68 | 3.53 | 0.21 | 0.48 | |
| Ag+ (0) | 75.26 | 24.38 | -- | 0.37 | -- | |
| Ag+ (30 days) | 72.88 | 26.88 | -- | 0.24 ↓ | -- | |
| Ag+ + PVP/PVA (0) | 73.47 | 25.97 | -- | 0.55 | -- | |
| Ag+ + PVP/PVA (30 days) | 75.39 | 24.22 | -- | 0.39 ↓ | -- | |
Disclaimer/Publisher’s Note: The statements, opinions and data contained in all publications are solely those of the individual author(s) and contributor(s) and not of MDPI and/or the editor(s). MDPI and/or the editor(s) disclaim responsibility for any injury to people or property resulting from any ideas, methods, instructions or products referred to in the content. |
© 2023 by the authors. Licensee MDPI, Basel, Switzerland. This article is an open access article distributed under the terms and conditions of the Creative Commons Attribution (CC BY) license (https://creativecommons.org/licenses/by/4.0/).
Share and Cite
Zhou, F.; Peng, J.; Tao, Y.; Yang, L.; Yang, D.; Sacher, E. The Enhanced Durability of AgCu Nanoparticle Coatings for Antibacterial Nonwoven Air Conditioner Filters. Molecules 2023, 28, 5446. https://doi.org/10.3390/molecules28145446
Zhou F, Peng J, Tao Y, Yang L, Yang D, Sacher E. The Enhanced Durability of AgCu Nanoparticle Coatings for Antibacterial Nonwoven Air Conditioner Filters. Molecules. 2023; 28(14):5446. https://doi.org/10.3390/molecules28145446
Chicago/Turabian StyleZhou, Fang, Jiabing Peng, Yujie Tao, Longlai Yang, Dequan Yang, and Edward Sacher. 2023. "The Enhanced Durability of AgCu Nanoparticle Coatings for Antibacterial Nonwoven Air Conditioner Filters" Molecules 28, no. 14: 5446. https://doi.org/10.3390/molecules28145446
APA StyleZhou, F., Peng, J., Tao, Y., Yang, L., Yang, D., & Sacher, E. (2023). The Enhanced Durability of AgCu Nanoparticle Coatings for Antibacterial Nonwoven Air Conditioner Filters. Molecules, 28(14), 5446. https://doi.org/10.3390/molecules28145446

